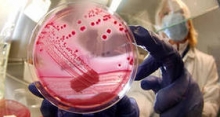
Салат, ролл и кишечная палочка

Объявления
БЛОГИ
ПОПУЛЯРНЫЕ ТОПИКИ

Коллективное заявление: в Общероссийский народный фронт, президенту Татарстана, мэру Челнов...
Общероссийский народный фронт, 119235, г. Москва, ул. Мосфильмовская, д. 40. post@onf.ru; Копии: Президенту республики Татарстан Минниханову Р.Н. Начальнику ГЖИ РТ Крайнову С.А. Начальнику НЧЗЖИ Мухаметдинову Ш.М Мэру города Набережные Челны Магдееву Н.Г. Прокурору Татарстана и города Набережные Челны Нафикову И.Ф и Евграфову А.П. от группы граждан - собственников, председателей и членов Советов МКД г.Набережные Челны.
2015-12-20 07:18:43
ПОСЛЕДНИЕ КОММЕНТАРИИ
Призыв сменить для Казани и Набережных Челнов часовой пояс не находит поддержки
2017-06-20 19:46:53
Мы летом должны жить в летнем времени, нам никчему рассветы ...
Призыв сменить для Казани и Набережных Челнов часовой пояс не находит поддержки
2017-06-20 13:56:03
А ничего, что эта публикация вышла без малого год назад, и ...
Призыв сменить для Казани и Набережных Челнов часовой пояс не находит поддержки
2017-06-20 11:22:24
Проблема заключается в том, что т.н. "московский часовой ...
Призыв сменить для Казани и Набережных Челнов часовой пояс не находит поддержки
2017-06-20 10:26:50
Ты тупой или просто баран?Объясни сюда людям, что изменится ...
Как я зарабатывал на Севере...
2017-06-19 20:28:50
Он все правильно сказал, в норильск как и во всю страну ...
Призыв сменить для Казани и Набережных Челнов часовой пояс не находит поддержки
2017-06-18 16:17:41
Даже с переводом часов на один час назад мы не стали ...
Призыв сменить для Казани и Набережных Челнов часовой пояс не находит поддержки
2017-06-18 16:17:19
21 июля 2014 года был принят Федеральный закон «О ...
Призыв сменить для Казани и Набережных Челнов часовой пояс не находит поддержки
2017-06-16 18:08:01
Этот сайт закроется когда-нибудь? Чего тут старые ...
Призыв сменить для Казани и Набережных Челнов часовой пояс не находит поддержки
2017-06-15 23:50:44
Вы че тут тупите! темнеет в 10 вечера в середине ...
Зачем нужны бойлеры в подвалах
2017-06-15 17:47:12
у нас, окозалось, есть бойлерплата за горячую воду ...
Татарстан примет 23400 легальных гастарбайтеров
2017-06-15 06:51:43
Кто сказал, что гатарбайтеры работают, у нас пол деревни ...
К 2050 году нехватка пахотной земли обернется продовольственным кризисом
2017-06-14 19:34:21
А ещё концов света было штук сто уже. И глобальных ...
Призыв сменить для Казани и Набережных Челнов часовой пояс не находит поддержки
2017-06-14 14:49:36
Заняться нечем? Проблем больше нет?
Рузаль Асадуллин ("29-й комплекс") отдал приказ убить в Москве 2 киллеров, которых наняли для него
2017-06-14 13:28:08
Лана точно знает, как он сидит. Наверное вместе чалится. ...
ОТВЕТЬ НА ВОПРОС!
Должно ли государство платить за медицинскую страховку для безработных?